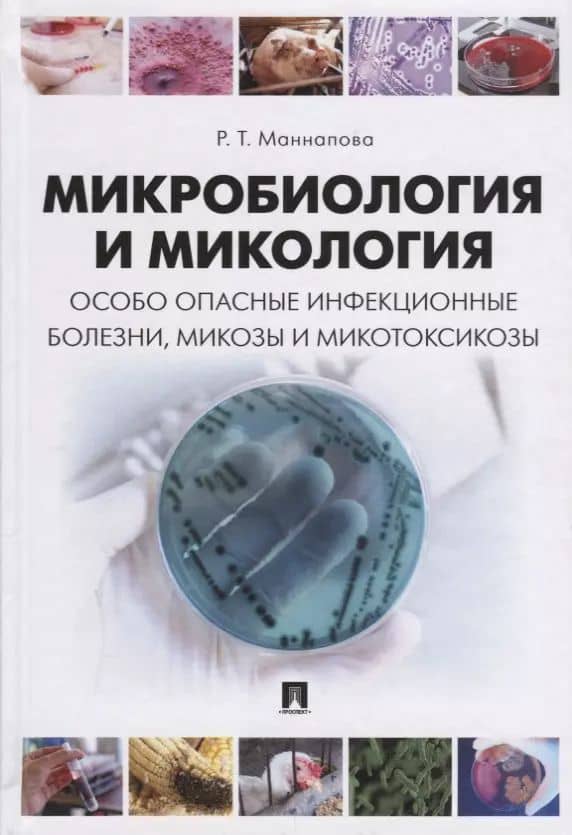

Микробиология и микология. Особо опасные инфекционные болезни, микозы и микотоксикозы. Учебник.

Учебник состоит из четырех разделов. Первый раздел содержит подробный материал о возбудителях особо опасных инфекционных болезней животных. Второй раздел посвящен микозам и кормовым микотоксикозам. Они составлены и изложены по единому плану. Третий раздел посвящен микробиологии продуктов животного происхождения. В четвертом разделе ко всем представленным в учебнике инфекционным болезням, микозам и микотоксикозам приведены схемы лабораторной диагностики и их специфической профилактики. В конце учебника представлен терминологический словарь, сведения об основоположниках микробиологии и иммунологии и лауреатах Нобелевской премии. Предназначен для подготовки специалистов с учетом требований программы ФГОС ВО по направлению 36.05.01 «Ветеринария». Учебник может быть использован при проведении занятий по выбору, факультативных занятий и научных исследований, а также при подготовке магистров/бакалавров по направлению 36.04.01/36.03.01 «Ветеринарно-санитарная экспертиза».
Go to description and details| Publisher | Проспект |
| Publication year | 2018 |
| ISBN | 978-5-392-27155-9 |
| Weight, g | 619 |
Учебник состоит из четырех разделов. Первый раздел содержит подробный материал о возбудителях особо опасных инфекционных болезней животных. Второй раздел посвящен микозам и кормовым микотоксикозам. Они составлены и изложены по единому плану. Третий раздел посвящен микробиологии продуктов животного происхождения. В четвертом разделе ко всем представленным в учебнике инфекционным болезням, микозам и микотоксикозам приведены схемы лабораторной диагностики и их специфической профилактики. В конце учебника представлен терминологический словарь, сведения об основоположниках микробиологии и иммунологии и лауреатах Нобелевской премии. Предназначен для подготовки специалистов с учетом требований программы ФГОС ВО по направлению 36.05.01 «Ветеринария». Учебник может быть использован при проведении занятий по выбору, факультативных занятий и научных исследований, а также при подготовке магистров/бакалавров по направлению 36.04.01/36.03.01 «Ветеринарно-санитарная экспертиза».
| Publisher | Проспект |
| Publication year | 2018 |
| ISBN | 978-5-392-27155-9 |
| Weight, g | 619 |